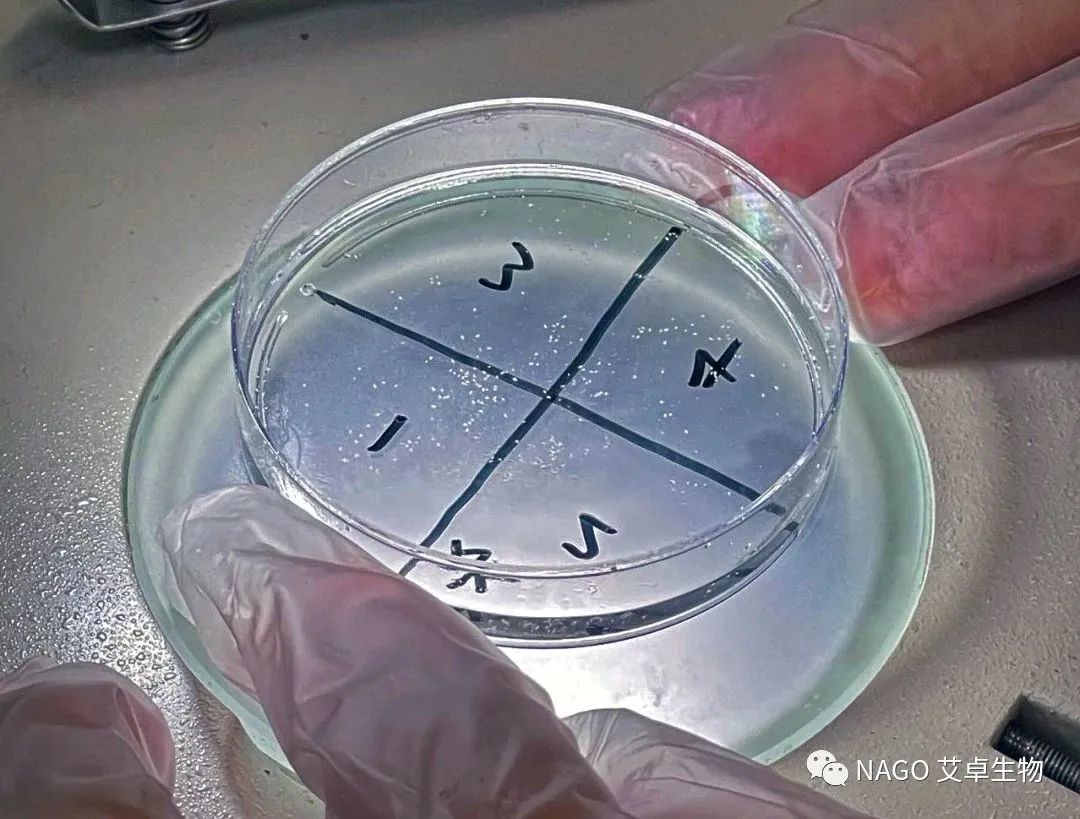

導(dǎo)語:塵螨是一種生活在溫暖潮濕環(huán)境的微小生物。就像一小顆不起眼的灰塵,卻常常出現(xiàn)在我們的家居環(huán)境中。它們成群結(jié)隊(duì)地爬行在你的被子、枕頭、沙發(fā)、地毯、窗簾上,吃著你掉落的皮屑,繁衍著它們的子子孫孫。
一、塵螨有什么危害?
塵螨的危害來自于它們自身和它們產(chǎn)生的代謝物,這些都是我們生活中常常接觸的強(qiáng)過敏原。一項(xiàng)調(diào)查表明,過敏性鼻炎患者對塵螨的過敏源陽性率高達(dá)90%,遠(yuǎn)高于雞蛋的53%、牛奶的52%、貓狗毛的25%和堅(jiān)果的15%。塵螨除了會誘發(fā)過敏性鼻炎,還可能誘發(fā)哮喘、濕疹、蕁麻疹等。

小朋友們在地毯上、沙發(fā)上、床上等地方玩耍時(shí),更容易和塵螨親密接觸,從而導(dǎo)致過敏。

有研究人員從2010年到2012年期間,在國內(nèi)10個(gè)城市,對將近5萬個(gè)3-6歲的兒童進(jìn)行關(guān)于過敏性疾病的調(diào)查,超過一半的兒童患有鼻炎、哮喘、濕疹中的至少一種,其中鼻炎的發(fā)病率高達(dá)24%~50.8%。在鼻炎患病率最高的武漢,超過一半的兒童患有鼻炎。其他城市的情況,感興趣的朋友可以仔細(xì)看看(見圖1)。兒童的過敏性疾病患病率在國內(nèi)呈不斷上升的趨勢,需要我們給予更多的關(guān)注

圖1 綠色為濕疹患病率,黃色為哮喘患病率,藍(lán)色為肺炎患病率,紅色為鼻炎患病率
如果環(huán)境適宜,食物豐富,塵螨的繁殖速度極快。雌性粉塵螨的壽命大約4個(gè)月,它的一生能產(chǎn)70顆卵,這些卵在一個(gè)月后可發(fā)育成能進(jìn)行交配的成熟螨蟲,繼續(xù)進(jìn)行產(chǎn)卵。假設(shè)家里的床上生活著一群粉塵螨,數(shù)量為200只,當(dāng)中大約有35只雌螨處于產(chǎn)卵期,這些雌螨可以產(chǎn)出大約2500顆卵。如此一來,這個(gè)粉塵螨家族在一個(gè)月后規(guī)模即可翻10 倍,從而產(chǎn)生大量的過敏原。

中國地域遼闊,塵螨的分布呈現(xiàn)南北差異。南方潮濕,塵螨密度高,北方和西部相對干燥,塵螨也相對少一些。有研究者基于機(jī)器學(xué)習(xí)建立了螨害風(fēng)險(xiǎn)預(yù)測模型,評估我國不同地區(qū)塵螨侵害風(fēng)險(xiǎn)等級(見圖2),預(yù)測結(jié)果也同樣體現(xiàn)了塵螨南多北少的特點(diǎn)。

圖2 中國不同地區(qū)塵螨侵害風(fēng)險(xiǎn)等級預(yù)測地圖
不同的季節(jié),塵螨的密度也存在變化。北京室內(nèi)塵螨的巔峰期是10月份,上海夏季時(shí)塵螨數(shù)量最多,廣東春冬季節(jié)塵螨數(shù)量多,尤其是春季。如果不及時(shí)采取行動,而任由塵螨肆意滋生,對塵螨過敏的朋友可能會招架不住來自塵螨的“回饋”。
二、塵螨長什么樣?
危害如此大的塵螨到底長什么樣子?
粉塵般的模樣,如不是刻意去尋找觀察,我們很難一睹其廬山真面目。想看到塵螨的形態(tài)細(xì)節(jié),需要通過顯微鏡放大至少幾十倍。
常見的塵螨有兩種,一種叫粉塵螨,另一種叫屋塵螨。它們個(gè)頭差不多,身體形態(tài)有一定的差別。
圖3 肉眼觀察到的粉塵螨

圖4 在顯微鏡下觀察到的粉塵螨
三、怎樣有效除螨?
當(dāng)塵螨的危害影響到正常生活,消費(fèi)者越發(fā)重視生活中的除螨問題,那怎樣使除螨效果更好呢?

目前已有的除螨措施主要分為物理性和化學(xué)性,物理性除螨方法有各類型的除螨儀,化學(xué)性除螨方法則有除螨噴霧、除螨沐浴露、除螨洗衣液等等。

家庭用的常規(guī)吸塵器或除螨儀僅能去除表面的塵螨,不能減少深部螨蟲的數(shù)量。因此,建議配合除螨產(chǎn)品共同進(jìn)行。
市面上大部分化學(xué)性除螨產(chǎn)品都含有化學(xué)合成的除螨成分,長期使用這類產(chǎn)品,對人體存在一定的副作用,特別是敏感肌人群和嬰童,皮膚組織較為脆弱,接觸后發(fā)生過敏反應(yīng)的可能性也會大大增加。

NAGO®凈螨易是一款純植物的除螨劑,除螨活性成分來源于金佛手、香茅、桉葉、薄荷、檸檬果、肉桂樹皮,通過合理的配比,使植物提取物發(fā)揮出溫和且高效的除螨效果,使消費(fèi)者能夠更加放心地使用除螨產(chǎn)品。
經(jīng)測試,在含有0.2%凈螨易的洗衣凝珠配方中,除螨率為100%▼

通過雞胚絨毛尿囊膜血管試驗(yàn)(CAMVA),0.2%凈螨易的NC值僅有1.375,此濃度表現(xiàn)溫和,對毛血細(xì)管沒有損傷性刺激。▼

最后想告訴大家,雖然螨蟲的繁殖速度快,數(shù)量多,但只要利用合理的方法,保持打理,家園就不會成為螨蟲的樂園,螨蟲也無法肆無忌憚的生長。
參考文獻(xiàn)


關(guān)閉

公眾號二維碼



